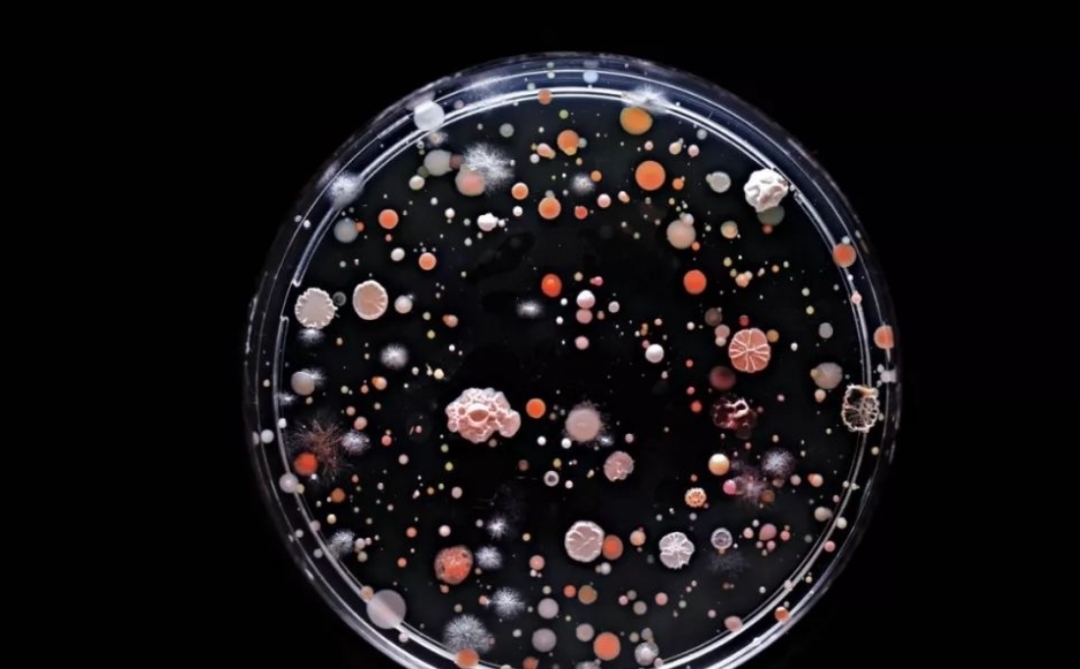

- · 《中国石油和化工标准与[08/03]
- · 《中国石油和化工标准与[08/03]
- · 《中国石油和化工标准与[08/03]
- · 《中国石油和化工标准与[08/03]
石油到底是怎么形成的?古代有这么多动植物尸(2)
作者:网站采编关键词:
摘要:河流冲刷两岸的河床泥沙 带入河、 已经被一定程度分解的有机物质 ,并且可以 被快速埋藏 。而且,有机物质沉积的位置宽广顺畅,可以 直接成为油气聚

地球是不断错落起伏运动着的,所以在一个地方蕴藏的石油并不是生成来源于此,水底不断垂直运动,蓄积无数层生物残骸,不断被压进地层深处经受高温高压,固体变流体,富集于低密度的岩石里在聚集在某处岩石形成的圈子里。

比如中东地区,以前那里是海,无数海洋微生物的残骸在这里聚集,经过地质运动,最终变成油藏。实际上,海洋微生物每天增加的质量虽然十分巨大,但因为物质循环的复杂性,沉降到海底淤泥中的并没有这么多,形成石油的比例还要进一步减小。然而,这个过程的时间是以亿万年计的。
因此,实际从生排烃,再到形成大规模的油藏,是一个很漫长并且条件很严格的过程。
古代有这么多动植物尸体累积成石油吗?

一般支持第二种说法的人都会质疑一个关键问题,古代有这么多动植物尸体累积成石油吗?他们认为,动植物的尸体不会直接变成石油,更为重要的是也没有那么多尸体累积起来变成石油。他们还曾使用猪来比喻,说全球石油储量约1966亿吨,如果是尸体变成的,就需要亿头猪的尸体,难道古代有这么多尸体埋下变成油吗?
他们还举出证据,认为如果是大型生物,必定有骨头,有钙,但是并不存在高钙石油。如果是某一种或几种微生物,在这些油井中,必然会普遍存在着这种微生物原生结构的主体元素。有这种现象吗?没有。石油和煤炭就是像一种天然存在的单质,只是因为埋藏过程中与周边的地层混杂了一下而已。

其实,在动植物最早开始在陆地上生长繁衍时,并没有产生微生物。这导致地球上动植物的尸体堆积得得非常厚。在地质沉降过程中,因为来不及得到分解而被掩埋。
尸体得不到分解,动植物的生命又有限,就会导致越来越多的动植物尸体堆积,才会形成了非常厚实密集的有机物,这些有机物跟随着地球运动,在上亿年的时间里,逐渐转换形式沉积合适的位置。所以,正是因为远古时期特殊的自然环境,和亿万年的时间长度,才使得这么多动植物累计。
所以,动植物的尸体是有可能产生地球储存的煤和石油的。随着时间推移,产生了可以分解植物的微生物,这才慢慢把超量的植物尸体给分解了。植物的发展一度太迅猛导致其他生物掉队,早期的地球植物和其他生物并不是保持共进退的关系。
科学不讲感情,也不讲逻辑和辩论。科学只讲证据。生物成油理论说之所以被广大接受,是因为有很多证据支持这种假说。
如果地球上从来就没有石油会怎么样?
按照生物成油理论,如果地球上从来就没有石油,那就意味着,在亿万年前,没有生物尸体跟随着地球运动带来的地质活动沉积,没有陆地海洋沧海桑田的变化,甚至没有时间的概念。

地球只是一个始终在宇宙中旋转着的干净水球,陆地上全是光秃秃的岩石和沙漠,没有植物,天空中全是毒气。也许没有条件进化出人类,所有生命可能静止,或者变成另外一种身份和形态,可能是尘埃,可能是水分子,也可能是毒气里的一粒,依旧牢牢依附在地球上。
按照非生物成油理论,那就意味着,地球内部即使从来没有含有这些成份,人类也许依旧能够发展到现在。只不过,是没有石油的世界。人类没有五颜六色的塑料瓶,没有纤维衣服,庄稼只能靠着最原始的肥料,可能还是坐马车牛车,地上不会有汽车,天上也不会有飞机,高楼也无法拔地而起。
文章来源:《中国石油和化工标准与质量》 网址: http://www.zgsyhhgbzyzl.cn/zonghexinwen/2022/0108/1127.html